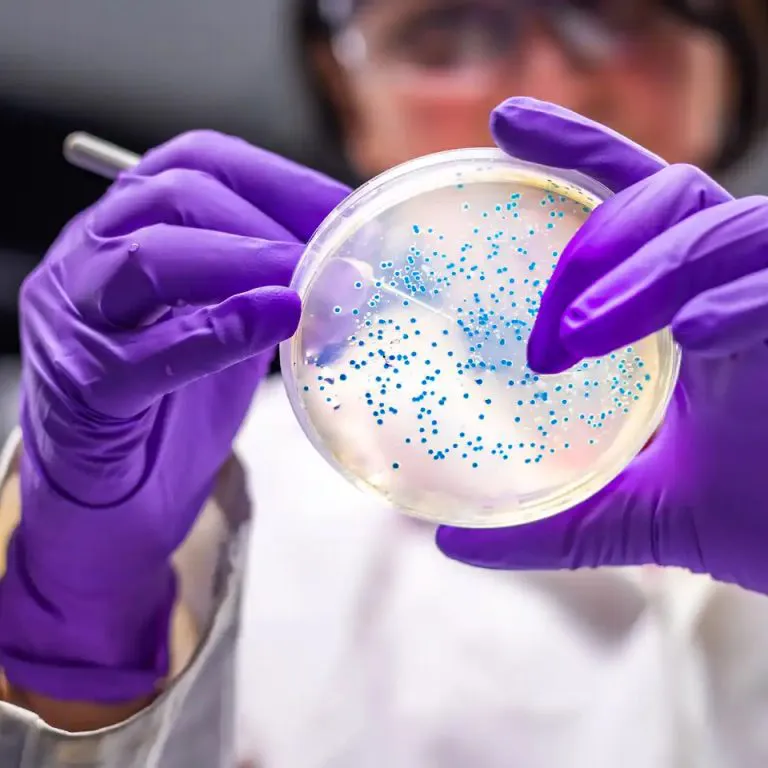
unt1

La Municipalidad de San Miguel de Tucumán realizó un taller destinado a médicos, enfermeros y nutricionistas que trabajan en el sistema municipal de salud.



La Universidad Nacional de Tucumán desarrolla una serie de acciones educativas; la iniciativa surge en el marco de la Semana Mundial de Concientización sobre el Uso de los Antibióticos. La Facultad de Bioquímica, Química y Farmacia (FBQyF) anunció una agenda de actividades; estas están orientadas a sensibilizar a la comunidad sobre la problemática global de la Resistencia Antimicrobiana (RAM). Este fenómeno representa uno de los desafíos sanitarios más urgentes de la actualidad; por ello, la institución decidió actuar.
Como parte de este trabajo constante, la institución llevará adelante un encuentro académico. Se trata de la 1° Jornada Estudiantil de Concientización; el tema principal será “Resistencia Antimicrobiana y su impacto en la sociedad”. El evento está destinado al público en general, no solo a los estudiantes de la universidad; busca aportar información científica de valor, entregar herramientas de prevención sencillas y promover un uso responsable de todos los antibióticos disponibles.
La actividad tendrá lugar el día veinte de noviembre; el horario estipulado va desde las 15:00 hasta las 17:30 horas, en el Aula Magna de la facultad, un espacio de alto valor simbólico. Dos académicos prestigiosos serán los principales disertantes; ellos compartirán sus conocimientos con los asistentes. El Doctor Juan Martín Vargas, profesor adjunto de la Cátedra de Bacteriología, será uno de ellos; la Bioquímica Cecilia María Lorca, jefa de Trabajos Prácticos de la misma cátedra, también expondrá su saber científico.
La propuesta formativa incluye la entrega de certificados oficiales; esto valida la participación de los asistentes. Además, posee un arancel accesible; el monto está destinado a colaborar directamente con la Cátedra de Bacteriología de la facultad. La inscripción formal es virtual y muy sencilla; se realiza mediante un formulario disponible en las redes sociales del Centro de Estudiantes, facilitando el acceso a todos los interesados, por lo que la participación se espera masiva.
La facultad invita a los alumnos a sumarse a la Práctica Social Educativa (PSE); esto complementa la jornada con una acción comunitaria. La iniciativa se vincula con el proyecto de extensión denominado “Intervenciones educativas como herramientas de concientización sobre la problemática de la resistencia antimicrobiana”. Este proyecto posee aprobación institucional; cuenta con la Resolución RES-FBQF-DEC-15358/2025, un aval importante. Esta iniciativa busca que los futuros profesionales de la salud se involucren activamente en acciones de educación sanitaria para la gente.

Ellos llevarán información accesible a las escuelas, a los centros de salud y a diversos espacios barriales. El objetivo primordial de esta acción es claro: fortalecer el compromiso social universitario con la gente; además, se busca contribuir activamente a frenar la propagación de infecciones resistentes a los tratamientos comunes. La Organización Mundial de la Salud considera la resistencia antimicrobiana como una de las principales amenazas para la salud pública; el uso inadecuado de los antibióticos favorece esta preocupante aparición de bacterias que ya no responden a la medicina.
Con todas estas actividades, la Universidad Nacional de Tucumán reafirma su rol clave en la formación de profesionales responsables, competentes en la materia. También ratifica su compromiso con la producción de conocimiento científico; además, busca activamente la transferencia de herramientas valiosas que impacten positivamente en toda la comunidad, cumpliendo así su función social.

La Municipalidad de San Miguel de Tucumán realizó un taller destinado a médicos, enfermeros y nutricionistas que trabajan en el sistema municipal de salud.

Por la conmemoración del Día del Registro Civil, este lunes no habrá atención en ninguna de las oficinas ni en los Centros de Documentación Rápida de Tucumán.

Alumnos de la UNT ganaron el concurso nacional “Los Materiales y la Humanidad”; el proyecto BA.D.I.A. propone una pieza de pavimento que gestiona el caudal de lluvia en urbes.

Por el Día Mundial de Reconocimiento de las Víctimas de Accidentes Viales, homenajearon a los damnificado, con un gesto de solidaridad y un llamado a la conciencia social.

El gobierno fortalece las herramientas teóricas y prácticas; busca la garantía y restitución de derechos de niños y adolescentes.

El Gymnasium de la UNT mejoró la formación científica de sus alumnos gracias a la donación de un microscopio para el estudio de la biología.

El Ministerio de Salud Pública realizó una jornada masiva para concientizar a la comunidad acerca de la enfermedad en el Complejo Belgrano.

La provincia con el Operativo Lapacho logro fortalecer las fronteras, gracias al trabajo coordinado de las fuerzas de seguridad con la justicia federal.

Las mejores sangucherias de Tucumán tendrán lugar en esta gran fiesta, donde intentarán armar el sánguche de milanesa más grande de la historia provincial.

La edición 38° del tradicional festival tendrá lugar el 14 y 15 de noviembre con grandes artistas, feria, gastronomía y propuestas para toda la familia.

El hombre había sido reportado como desaparecido desde el pasado viernes 7 de noviembre, cuando salió de su casa después de llevar a su hijo al colegio.

Franco Colapinto, Nico Varrone y Matías Colnaghi hacen historia, por primera vez tres pilotos argentinos van a competir simultáneamente en F1, F2 y F3.

Desde la Secretaría de Movilidad Urbana informaron que el trámite es gratuito, muy sencillo y puede realizarse directamente en los colectivos.

El Torneo Clausura finaliza este fin de semana y solo uno asegurará su permanencia, mientras que los otros dos jugarán en la B Nacional el año que viene.